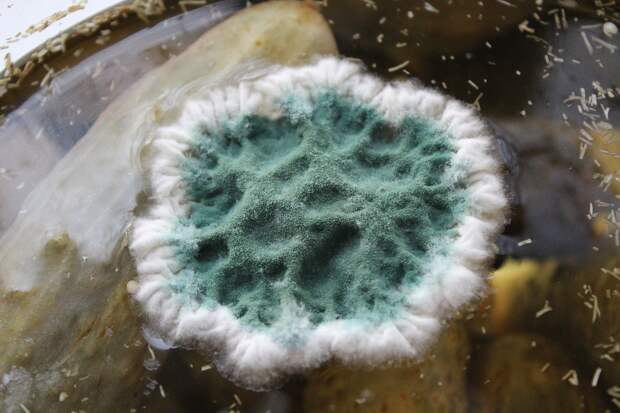

Крупнейший в Латинской Америке завод по производству биоматериалов откроется в Бразилии к концу 2023 года, 20 января сообщается на онлайн-платформе AgroPages. Компания Crop Care запланировала построить завод в городе Итаполис в бразильском штате Сан-Паулу. Для этого уже приобретена земля. Crop Care недавно приобрела компанию Agrobiológica, у которой есть три завода в том же штате Сан-Паулу.
Марсело Пессанья, генеральный директор Crop Care, объявил, что компания инвестирует 100 млн бразильских реалов (1,352 млрд руб), чтобы в пять раз увеличить производство биоресурсов, а также расширить исследования этих продуктов. «Мы производим самый разнообразный ассортимент биоресурсов, которые представляют собой продукты, используемые в сельском хозяйстве с той же целью, что и агрохимикаты, но с тем преимуществом, что они не наносят ущерба окружающей среде или людям», — заявил Пессанья. Он добавил, что компания собирается увеличить свои производственные мощности в пять раз, и подчеркнул, что сегмент биоресурсов рос почти на 50% в год и должен поддерживать двузначный рост в течение следующих пяти лет. «Восемь из десяти фермеров уже используют биоресурсы», — сказал Пессанья, обратив внимание, что использование этих устойчивых продуктов в агробизнесе отразится на среднесрочном падении цен на продукты питания для потребителей. «Помимо биоресурсов, мы работаем с агрохимикатами через другую компанию под названием Perterra. Этот сектор гораздо более стратегический с точки зрения снижения рисков высокой зависимости от китайских и индийских поставщиков», — пояснил глава Crop Care.
Свежие комментарии